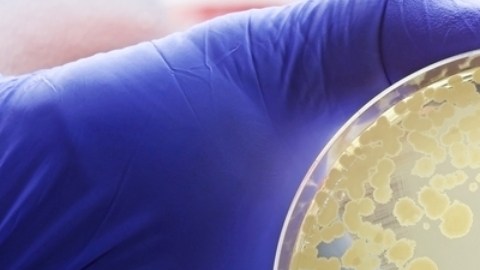

Casi 40 millones de personas en 2050 podrían morir por crisis de superbacterias
La resistencia a los antimicrobianos podría causar 39 millones de muertes entre 2025 y 2050, según un estudio
El mal uso y abuso de los antibióticos en humanos, animales y plantas ha acelerado la propagación de patógenos resistentes. Crédito: TopMicrobialStock | Shutterstock
Un nuevo estudio advierte que la resistencia a los antimicrobianos (RAM) representa una amenaza creciente para la salud mundial, con una proyección de más de 39 millones de muertes entre 2025 y 2050.
Este problema surge cuando bacterias, hongos y otros patógenos desarrollan la capacidad de resistir los efectos de los medicamentos diseñados para eliminarlos. La comunidad científica y médica ha mostrado su preocupación ante un posible aumento del 70% en las muertes causadas por infecciones resistentes para 2050.

El análisis, que se publicó en la revista The Lancet, fue dirigido por el Dr. Chris Murray, director del Instituto de Métricas y Evaluación de la Salud de la Universidad de Washington. M
urray destaca que, si no se toman medidas inmediatas, la situación podría empeorar, subrayando la necesidad de un uso más racional y controlado de los antibióticos. Para abordar esto, se requiere un enfoque integral que promueva tanto el desarrollo de nuevos medicamentos como la implementación de estrategias para un uso adecuado de los actuales.
La Organización Mundial de la Salud (OMS) ya había alertado sobre los riesgos de la RAM, considerándola una de las mayores amenazas para la salud pública. El mal uso y abuso de los antibióticos en humanos, animales y plantas ha acelerado la propagación de patógenos resistentes, lo que agrava el problema.
Según el estudio, a menos que se tomen acciones decisivas, las muertes por infecciones resistentes continuarán aumentando, con graves consecuencias para las poblaciones vulnerables.
El equipo de investigadores involucrado en este trabajo analizó datos de 204 países entre 1990 y 2021, evaluando la prevalencia de 22 patógenos y las infecciones más comunes asociadas con la resistencia a los antimicrobianos. A través de modelos estadísticos, los expertos pudieron prever el impacto que tendrá la RAM en los próximos años.
Mientras que las muertes en niños menores de 5 años disminuyeron en más del 50%, las muertes entre adultos mayores de 70 años aumentaron en más del 80%.
Infecciones más letales
Uno de los aspectos es el crecimiento en la resistencia del Staphylococcus aureus a la meticilina (SARM), una de las infecciones más letales. Entre 1990 y 2021, las muertes atribuibles a este patógeno casi se duplicaron, alcanzando 130,000 víctimas anuales.
Si las condiciones actuales persisten, se estima que en 2050 el número de muertes atribuibles a la resistencia a los antimicrobianos podría llegar a 1.9 millones, y las asociadas con la RAM podrían sumar hasta 8.2 millones.

Además, las regiones más afectadas serán Asia del Sur, América Latina, el Caribe y África subsahariana, donde la falta de acceso equitativo a la atención médica complica aún más la situación. En muchos países con recursos limitados, los pacientes no reciben los tratamientos necesarios, lo que agrava el impacto de las infecciones.
Este enfoque preventivo es crucial, ya que la aparición de nuevas superbacterias sigue siendo una amenaza latente. Los expertos advierten que, si no se adoptan medidas para contrarrestar este desafío, las previsiones actuales podrían incluso subestimar el impacto real de la RAM.
Sigue leyendo: